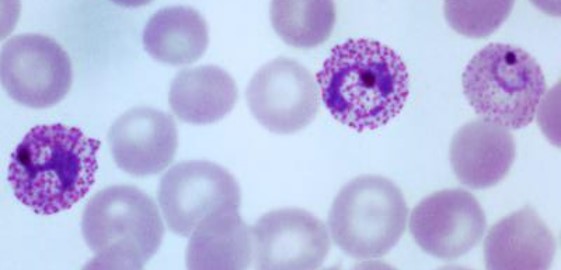

Biol 1031 Practical
5.0(2)
Studied by 106 peopleCard Sorting
1/55
Earn XP
Last updated 9:38 PM on 2/22/23
Name | Mastery | Learn | Test | Matching | Spaced | Call with Kai |
|---|
No analytics yet
Send a link to your students to track their progress
56 Terms
1
New cards
Radiolaria
\

2
New cards
Foraminifera

3
New cards
Gymnamoeba

4
New cards
Ciliophora
\

5
New cards
euglenozoa

6
New cards
Trypanosomes
7
New cards
Myxogastridia

8
New cards
Phaeophyta

9
New cards
Chlorophyta

10
New cards
Rhodophyta

11
New cards
Phaeophyta

12
New cards
Chlorophyta

13
New cards
zygotic meiosis

14
New cards
Gametic meiosis

15
New cards
sporic meiosis

16
New cards
Anthocerophyta

17
New cards
Bryophyta

18
New cards
Hepatophyta

19
New cards
Anthocerophyta

20
New cards
Antheridial Head

21
New cards
Antheridial head

22
New cards
Archegonial Head

23
New cards
Archegonial Head

24
New cards
Psilophyta

25
New cards
Arthrophyta

26
New cards
Lycophyta

27
New cards
Lycophyta

28
New cards
Sori

29
New cards
Pterophyta

30
New cards
Prothallus

31
New cards
Prothallus

32
New cards
Pterophyta

33
New cards
sori

34
New cards
Cycadophyta

35
New cards
Ginkophyta

36
New cards
Gnetophyta

37
New cards
Coniferophyta

38
New cards
Coniferophyta

39
New cards
Homospory + elaters

40
New cards
Heterospory

41
New cards
elater microscope slide

42
New cards
micropyle slide

43
New cards
pollen grain slide

44
New cards
monocot and eudicot

45
New cards
connate

46
New cards

47
New cards

48
New cards
radial symmetry

49
New cards
Bilateral symmetry

50
New cards
simple dry

51
New cards
multiple fleshy

52
New cards
simple fleshy accessory

53
New cards
simple fleshy

54
New cards
aggregate dry accessory

55
New cards
simple fleshy accessory

56
New cards
simple fleshy
